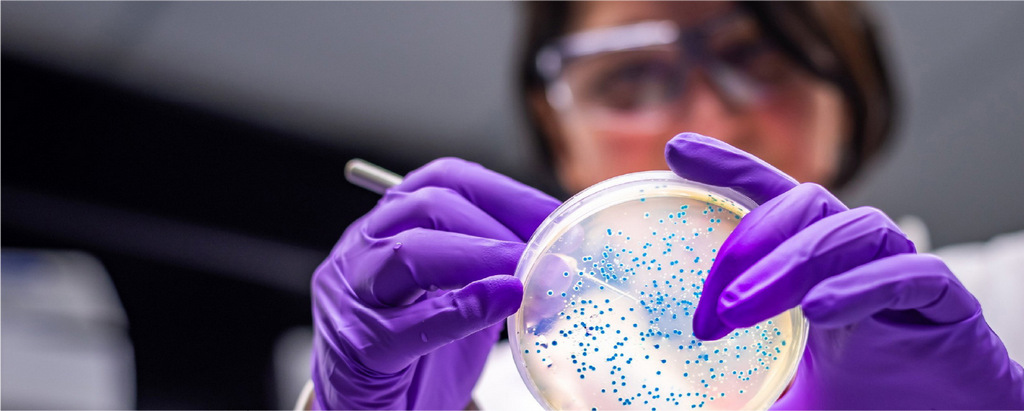
Биотех Upstream Bio подает заявку на IPO на сумму $100 млн

Продукты
Инструменты
Регулирование и защита
Ресурсы

Биотехнологическая компания Upstream Bio подала в среду заявку в Комиссию по ценным бумагам и биржам США (SEC) c оценкой IPO до $100 млн. Ранее, 12 июня, была подана конфиденциальная заявка. Upstream занимается разработкой антител для лечения респираторных заболеваний; один из препаратов компании находится во второй фазе клинических испытаний для лечения тяжелой астмы и хронического риносинусита.
Лаборатория была основа в штате Массачусетс 3 года назад. Заработок за последние 12 месяцев составил $2 млн. Выход молодой команды на фондовую биржу сопровождают инвестбанки J.P. Morgan, TD Cowen, Piper Sandler и William Blair. Компания планирует разместить акции на бирже Nasdaq под тикером UPB.
Источник: Renaissance Capital
→ Если заинтересовались инвестициями с помощью ИИ, то лучше всего начать погружаться в эту тему с нашей статьи База знаний о портфельных инвестициях Investlink с использованием ИИ.
Salesforce и NVIDIA объединяются для продвижения нового направления ИИ
Microsoft планирует выкупить свои акции на $60 млрд
Многомиллиардные сделки с Amazon и армией США возвращают Intel в центр внимания

Заполните форму, чтобы получить профессиональную инвестиционную консультацию бесплатно.

Наведите камеру телефона на QR-код,
чтобы скачать мобильное приложение.
